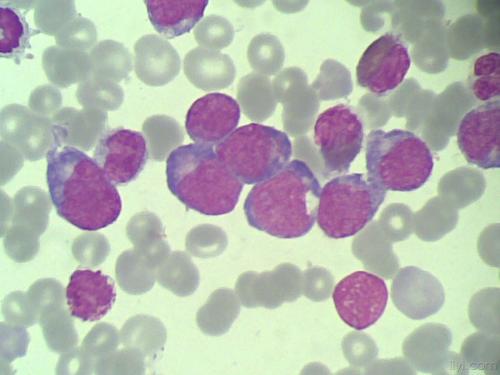

急性髓细胞性白血病(AML)是一种致命的血液癌,起源于骨髓,五年内杀死了大部分受害者。化疗已成为40多年来标准的AML治疗方法,尽管它通常会导致癌症缓解,但很少能完全清除癌细胞,从而导致将近一半的患者复发疾病。积极的缓解后治疗,例如大剂量化学疗法或骨髓移植,可以减少复发的机会,但是许多AML患者的健康状况尚不能耐受。 现在,一项新的研究提出了一种可以完全消除AML细胞的替代疗法:一种可注射的,基于生物材料的疫苗,当与标准化学疗法结合使用时,可以从小鼠中完全持久地恢复AML并对其产生免疫力。该研究由哈佛大学Wyss生物启发工程研究所,约翰·保尔森工程与应用科学学院(SEAS)和干细胞研究所(SCI)的研究人员进行,并发表在《自然生物医学工程》上。共同第一作者,前博士后研究员Nisarg Shah博士说:“我们以前已经开发出了针对实体瘤的癌症疫苗,我们很想知道这项技术是否还能有效治疗像AML这样的血液癌症。”在Wyss核心教职员工David Mooney博士的实验室中。现在是加利福尼亚大学圣地亚哥分校的助理教授。这种疫苗与化学疗法结合的有希望的结果可能会转化为人类疫苗,这种疫苗可以个性化,但提供现成的便利。”狡猾的冰冻凝胶像其他疫苗一样,AML疫苗“教”人体的免疫系统识别外来入侵者(在这种情况下为AML癌细胞),以便在入侵者出现时可以发起有效的攻击。传统疫苗通常是液体,而这种疫苗是一种微小的盘状“ cryogel”支架,主要由两种材料(聚乙二醇和藻酸盐)制成,它们已经交联在一起形成基质。两种化学药品(GM-CSF和CpG-ODN)嵌入支架中,以吸引人体的树突状细胞并激活它们,以及AML细胞特有的抗原(来自死AML细胞的内容物或来自WT-1蛋白的肽) 。活化的树突状细胞从疫苗位点吸收抗原,并将其呈递给T细胞,从而触发它们寻找并破坏AML细胞,并希望为了测试他们的冷冻凝胶疫苗是否有效地激发了免疫系统攻击AML细胞,研究小组将其注射到健康小鼠的皮肤下,发现当AML细胞含量或WT-1含量高时,它会导致激活的T细胞数量增加与通过传统疫苗注射或不添加任何化学物质的“空白”支架接受活化化学物质的小鼠相比,它被用作抗原。然后,他们通过向小鼠注射表达WT-1的AML细胞来“挑战”小鼠,以模仿疾病的初始发作。接受传统疫苗或空白支架的小鼠在60天内死于该疾病,而接受冷冻凝胶疫苗的小鼠存活。然后,幸存者在100天后再次受到第二剂量的AML细胞的攻击,并且没有疾病迹象,由于AML起源于骨髓,癌细胞可以“隐藏”在那里以逃避化学疗法的治疗,因此研究小组分析了小鼠的骨髓。他们在冷冻凝胶疫苗接种的小鼠骨髓中发现了大量活跃的T细胞,而没有发现AML细胞。当他们将这些小鼠的骨髓移植到健康小鼠中,然后再用AML细胞攻击后,所有的移植接受者都存活了下来,而对照组的小鼠在30天内死于AML,这表明针对AML的免疫保护是持续的和可转移的。出乎意料的结果,胜于预期的结果为了更紧密地模拟人类患者发展为AML的临床情况,研究小组将其冷冻凝胶疫苗注射入患有AML的小鼠以及AML患者接受的标准化疗方案,这导致AML细胞大量死亡。接受联合疗法的小鼠中活化的T细胞反应比接受化学疗法加传统液体疫苗的小鼠高六倍,这表明冷冻凝胶是将活化化学物质输送至免疫系统的更有效的载体。为了测试联合治疗产生的免疫应答的持久性,他们从小鼠身上收获了骨髓,这些小鼠接种了带有WT-1肽的冷冻凝胶疫苗以及化学疗法,然后将其移植到健康的小鼠中,然后再接受AML攻击。移植后最多14天,没有一只受体小鼠发生AML,这表明经组合治疗的小鼠的骨髓中没有残留的AML细胞,并且所有的受体小鼠在后来的AML细胞攻击下都存活了下来,而未经治疗的小鼠在31天内死亡。但是,当研究人员开始修补疫苗的成分以研究其为何如此有效时,他们发现了完全出乎意料的事情:不含AML抗原的疫苗在提供保护方面与含有AML细胞或野生型疫苗的疫苗一样有效。 -1肽。“我们绝对感到惊讶,并且真的没想到会有这个结果,因为我们最初认为在疫苗中包含抗原是至关重要的。这导致我们沿着以前没有考虑过尝试去了解正在发生的事情的一些研究途径, ”第一作者,门尼实验室研究生Alex Najibi说。“我们发现AML细胞实际上会随时间进入冷冻凝胶,在树突状细胞已经被浓缩并被激活的地方。当化学作用导致大量AML细胞死亡时,树突状细胞可以捡拾其残留物作为抗原并产生强信号。激活针对AML的T细胞。”为了进一步评估其无抗原疫苗和化学疗法组合的功效,研究小组分析了单独接受该组合或无抗原疫苗的AML小鼠的骨髓。他们发现单独的无抗原疫苗并不能有效地减少骨髓中AML细胞的数量或增加活性T细胞的数量,但是联合疗法实现了这两个目标。该组合还导致骨髓中调节性T细胞(Tregs)数量减少,从而抑制了免疫功能,被认为是骨髓中AML细胞可以逃避免疫检测的主要原因。
现在,一项新的研究提出了一种可以完全消除AML细胞的替代疗法:一种可注射的,基于生物材料的疫苗,当与标准化学疗法结合使用时,可以从小鼠中完全持久地恢复AML并对其产生免疫力。该研究由哈佛大学Wyss生物启发工程研究所,约翰·保尔森工程与应用科学学院(SEAS)和干细胞研究所(SCI)的研究人员进行,并发表在《自然生物医学工程》上。共同第一作者,前博士后研究员Nisarg Shah博士说:“我们以前已经开发出了针对实体瘤的癌症疫苗,我们很想知道这项技术是否还能有效治疗像AML这样的血液癌症。”在Wyss核心教职员工David Mooney博士的实验室中。现在是加利福尼亚大学圣地亚哥分校的助理教授。这种疫苗与化学疗法结合的有希望的结果可能会转化为人类疫苗,这种疫苗可以个性化,但提供现成的便利。”狡猾的冰冻凝胶像其他疫苗一样,AML疫苗“教”人体的免疫系统识别外来入侵者(在这种情况下为AML癌细胞),以便在入侵者出现时可以发起有效的攻击。传统疫苗通常是液体,而这种疫苗是一种微小的盘状“ cryogel”支架,主要由两种材料(聚乙二醇和藻酸盐)制成,它们已经交联在一起形成基质。两种化学药品(GM-CSF和CpG-ODN)嵌入支架中,以吸引人体的树突状细胞并激活它们,以及AML细胞特有的抗原(来自死AML细胞的内容物或来自WT-1蛋白的肽) 。活化的树突状细胞从疫苗位点吸收抗原,并将其呈递给T细胞,从而触发它们寻找并破坏AML细胞,并希望为了测试他们的冷冻凝胶疫苗是否有效地激发了免疫系统攻击AML细胞,研究小组将其注射到健康小鼠的皮肤下,发现当AML细胞含量或WT-1含量高时,它会导致激活的T细胞数量增加与通过传统疫苗注射或不添加任何化学物质的“空白”支架接受活化化学物质的小鼠相比,它被用作抗原。然后,他们通过向小鼠注射表达WT-1的AML细胞来“挑战”小鼠,以模仿疾病的初始发作。接受传统疫苗或空白支架的小鼠在60天内死于该疾病,而接受冷冻凝胶疫苗的小鼠存活。然后,幸存者在100天后再次受到第二剂量的AML细胞的攻击,并且没有疾病迹象,由于AML起源于骨髓,癌细胞可以“隐藏”在那里以逃避化学疗法的治疗,因此研究小组分析了小鼠的骨髓。他们在冷冻凝胶疫苗接种的小鼠骨髓中发现了大量活跃的T细胞,而没有发现AML细胞。当他们将这些小鼠的骨髓移植到健康小鼠中,然后再用AML细胞攻击后,所有的移植接受者都存活了下来,而对照组的小鼠在30天内死于AML,这表明针对AML的免疫保护是持续的和可转移的。出乎意料的结果,胜于预期的结果为了更紧密地模拟人类患者发展为AML的临床情况,研究小组将其冷冻凝胶疫苗注射入患有AML的小鼠以及AML患者接受的标准化疗方案,这导致AML细胞大量死亡。接受联合疗法的小鼠中活化的T细胞反应比接受化学疗法加传统液体疫苗的小鼠高六倍,这表明冷冻凝胶是将活化化学物质输送至免疫系统的更有效的载体。为了测试联合治疗产生的免疫应答的持久性,他们从小鼠身上收获了骨髓,这些小鼠接种了带有WT-1肽的冷冻凝胶疫苗以及化学疗法,然后将其移植到健康的小鼠中,然后再接受AML攻击。移植后最多14天,没有一只受体小鼠发生AML,这表明经组合治疗的小鼠的骨髓中没有残留的AML细胞,并且所有的受体小鼠在后来的AML细胞攻击下都存活了下来,而未经治疗的小鼠在31天内死亡。但是,当研究人员开始修补疫苗的成分以研究其为何如此有效时,他们发现了完全出乎意料的事情:不含AML抗原的疫苗在提供保护方面与含有AML细胞或野生型疫苗的疫苗一样有效。 -1肽。“我们绝对感到惊讶,并且真的没想到会有这个结果,因为我们最初认为在疫苗中包含抗原是至关重要的。这导致我们沿着以前没有考虑过尝试去了解正在发生的事情的一些研究途径, ”第一作者,门尼实验室研究生Alex Najibi说。“我们发现AML细胞实际上会随时间进入冷冻凝胶,在树突状细胞已经被浓缩并被激活的地方。当化学作用导致大量AML细胞死亡时,树突状细胞可以捡拾其残留物作为抗原并产生强信号。激活针对AML的T细胞。”为了进一步评估其无抗原疫苗和化学疗法组合的功效,研究小组分析了单独接受该组合或无抗原疫苗的AML小鼠的骨髓。他们发现单独的无抗原疫苗并不能有效地减少骨髓中AML细胞的数量或增加活性T细胞的数量,但是联合疗法实现了这两个目标。该组合还导致骨髓中调节性T细胞(Tregs)数量减少,从而抑制了免疫功能,被认为是骨髓中AML细胞可以逃避免疫检测的主要原因。
现在,一项新的研究提出了一种可以完全消除AML细胞的替代疗法:一种可注射的,基于生物材料的疫苗,当与标准化学疗法结合使用时,可以从小鼠中完全持久地恢复AML并对其产生免疫力。该研究由哈佛大学Wyss生物启发工程研究所,约翰·保尔森工程与应用科学学院(SEAS)和干细胞研究所(SCI)的研究人员进行,并发表在《自然生物医学工程》上。共同第一作者,前博士后研究员Nisarg Shah博士说:“我们以前已经开发出了针对实体瘤的癌症疫苗,我们很想知道这项技术是否还能有效治疗像AML这样的血液癌症。”在Wyss核心教职员工David Mooney博士的实验室中。现在是加利福尼亚大学圣地亚哥分校的助理教授。这种疫苗与化学疗法结合的有希望的结果可能会转化为人类疫苗,这种疫苗可以个性化,但提供现成的便利。”狡猾的冰冻凝胶像其他疫苗一样,AML疫苗“教”人体的免疫系统识别外来入侵者(在这种情况下为AML癌细胞),以便在入侵者出现时可以发起有效的攻击。传统疫苗通常是液体,而这种疫苗是一种微小的盘状“ cryogel”支架,主要由两种材料(聚乙二醇和藻酸盐)制成,它们已经交联在一起形成基质。两种化学药品(GM-CSF和CpG-ODN)嵌入支架中,以吸引人体的树突状细胞并激活它们,以及AML细胞特有的抗原(来自死AML细胞的内容物或来自WT-1蛋白的肽) 。活化的树突状细胞从疫苗位点吸收抗原,并将其呈递给T细胞,从而触发它们寻找并破坏AML细胞,并希望为了测试他们的冷冻凝胶疫苗是否有效地激发了免疫系统攻击AML细胞,研究小组将其注射到健康小鼠的皮肤下,发现当AML细胞含量或WT-1含量高时,它会导致激活的T细胞数量增加与通过传统疫苗注射或不添加任何化学物质的“空白”支架接受活化化学物质的小鼠相比,它被用作抗原。然后,他们通过向小鼠注射表达WT-1的AML细胞来“挑战”小鼠,以模仿疾病的初始发作。接受传统疫苗或空白支架的小鼠在60天内死于该疾病,而接受冷冻凝胶疫苗的小鼠存活。然后,幸存者在100天后再次受到第二剂量的AML细胞的攻击,并且没有疾病迹象,由于AML起源于骨髓,癌细胞可以“隐藏”在那里以逃避化学疗法的治疗,因此研究小组分析了小鼠的骨髓。他们在冷冻凝胶疫苗接种的小鼠骨髓中发现了大量活跃的T细胞,而没有发现AML细胞。当他们将这些小鼠的骨髓移植到健康小鼠中,然后再用AML细胞攻击后,所有的移植接受者都存活了下来,而对照组的小鼠在30天内死于AML,这表明针对AML的免疫保护是持续的和可转移的。出乎意料的结果,胜于预期的结果为了更紧密地模拟人类患者发展为AML的临床情况,研究小组将其冷冻凝胶疫苗注射入患有AML的小鼠以及AML患者接受的标准化疗方案,这导致AML细胞大量死亡。接受联合疗法的小鼠中活化的T细胞反应比接受化学疗法加传统液体疫苗的小鼠高六倍,这表明冷冻凝胶是将活化化学物质输送至免疫系统的更有效的载体。为了测试联合治疗产生的免疫应答的持久性,他们从小鼠身上收获了骨髓,这些小鼠接种了带有WT-1肽的冷冻凝胶疫苗以及化学疗法,然后将其移植到健康的小鼠中,然后再接受AML攻击。移植后最多14天,没有一只受体小鼠发生AML,这表明经组合治疗的小鼠的骨髓中没有残留的AML细胞,并且所有的受体小鼠在后来的AML细胞攻击下都存活了下来,而未经治疗的小鼠在31天内死亡。但是,当研究人员开始修补疫苗的成分以研究其为何如此有效时,他们发现了完全出乎意料的事情:不含AML抗原的疫苗在提供保护方面与含有AML细胞或野生型疫苗的疫苗一样有效。 -1肽。“我们绝对感到惊讶,并且真的没想到会有这个结果,因为我们最初认为在疫苗中包含抗原是至关重要的。这导致我们沿着以前没有考虑过尝试去了解正在发生的事情的一些研究途径, ”第一作者,门尼实验室研究生Alex Najibi说。“我们发现AML细胞实际上会随时间进入冷冻凝胶,在树突状细胞已经被浓缩并被激活的地方。当化学作用导致大量AML细胞死亡时,树突状细胞可以捡拾其残留物作为抗原并产生强信号。激活针对AML的T细胞。”为了进一步评估其无抗原疫苗和化学疗法组合的功效,研究小组分析了单独接受该组合或无抗原疫苗的AML小鼠的骨髓。他们发现单独的无抗原疫苗并不能有效地减少骨髓中AML细胞的数量或增加活性T细胞的数量,但是联合疗法实现了这两个目标。该组合还导致骨髓中调节性T细胞(Tregs)数量减少,从而抑制了免疫功能,被认为是骨髓中AML细胞可以逃避免疫检测的主要原因。
现在,一项新的研究提出了一种可以完全消除AML细胞的替代疗法:一种可注射的,基于生物材料的疫苗,当与标准化学疗法结合使用时,可以从小鼠中完全持久地恢复AML并对其产生免疫力。该研究由哈佛大学Wyss生物启发工程研究所,约翰·保尔森工程与应用科学学院(SEAS)和干细胞研究所(SCI)的研究人员进行,并发表在《自然生物医学工程》上。共同第一作者,前博士后研究员Nisarg Shah博士说:“我们以前已经开发出了针对实体瘤的癌症疫苗,我们很想知道这项技术是否还能有效治疗像AML这样的血液癌症。”在Wyss核心教职员工David Mooney博士的实验室中。现在是加利福尼亚大学圣地亚哥分校的助理教授。这种疫苗与化学疗法结合的有希望的结果可能会转化为人类疫苗,这种疫苗可以个性化,但提供现成的便利。”狡猾的冰冻凝胶像其他疫苗一样,AML疫苗“教”人体的免疫系统识别外来入侵者(在这种情况下为AML癌细胞),以便在入侵者出现时可以发起有效的攻击。传统疫苗通常是液体,而这种疫苗是一种微小的盘状“ cryogel”支架,主要由两种材料(聚乙二醇和藻酸盐)制成,它们已经交联在一起形成基质。两种化学药品(GM-CSF和CpG-ODN)嵌入支架中,以吸引人体的树突状细胞并激活它们,以及AML细胞特有的抗原(来自死AML细胞的内容物或来自WT-1蛋白的肽) 。活化的树突状细胞从疫苗位点吸收抗原,并将其呈递给T细胞,从而触发它们寻找并破坏AML细胞,并希望为了测试他们的冷冻凝胶疫苗是否有效地激发了免疫系统攻击AML细胞,研究小组将其注射到健康小鼠的皮肤下,发现当AML细胞含量或WT-1含量高时,它会导致激活的T细胞数量增加与通过传统疫苗注射或不添加任何化学物质的“空白”支架接受活化化学物质的小鼠相比,它被用作抗原。然后,他们通过向小鼠注射表达WT-1的AML细胞来“挑战”小鼠,以模仿疾病的初始发作。接受传统疫苗或空白支架的小鼠在60天内死于该疾病,而接受冷冻凝胶疫苗的小鼠存活。然后,幸存者在100天后再次受到第二剂量的AML细胞的攻击,并且没有疾病迹象,由于AML起源于骨髓,癌细胞可以“隐藏”在那里以逃避化学疗法的治疗,因此研究小组分析了小鼠的骨髓。他们在冷冻凝胶疫苗接种的小鼠骨髓中发现了大量活跃的T细胞,而没有发现AML细胞。当他们将这些小鼠的骨髓移植到健康小鼠中,然后再用AML细胞攻击后,所有的移植接受者都存活了下来,而对照组的小鼠在30天内死于AML,这表明针对AML的免疫保护是持续的和可转移的。出乎意料的结果,胜于预期的结果为了更紧密地模拟人类患者发展为AML的临床情况,研究小组将其冷冻凝胶疫苗注射入患有AML的小鼠以及AML患者接受的标准化疗方案,这导致AML细胞大量死亡。接受联合疗法的小鼠中活化的T细胞反应比接受化学疗法加传统液体疫苗的小鼠高六倍,这表明冷冻凝胶是将活化化学物质输送至免疫系统的更有效的载体。为了测试联合治疗产生的免疫应答的持久性,他们从小鼠身上收获了骨髓,这些小鼠接种了带有WT-1肽的冷冻凝胶疫苗以及化学疗法,然后将其移植到健康的小鼠中,然后再接受AML攻击。移植后最多14天,没有一只受体小鼠发生AML,这表明经组合治疗的小鼠的骨髓中没有残留的AML细胞,并且所有的受体小鼠在后来的AML细胞攻击下都存活了下来,而未经治疗的小鼠在31天内死亡。但是,当研究人员开始修补疫苗的成分以研究其为何如此有效时,他们发现了完全出乎意料的事情:不含AML抗原的疫苗在提供保护方面与含有AML细胞或野生型疫苗的疫苗一样有效。 -1肽。“我们绝对感到惊讶,并且真的没想到会有这个结果,因为我们最初认为在疫苗中包含抗原是至关重要的。这导致我们沿着以前没有考虑过尝试去了解正在发生的事情的一些研究途径, ”第一作者,门尼实验室研究生Alex Najibi说。“我们发现AML细胞实际上会随时间进入冷冻凝胶,在树突状细胞已经被浓缩并被激活的地方。当化学作用导致大量AML细胞死亡时,树突状细胞可以捡拾其残留物作为抗原并产生强信号。激活针对AML的T细胞。”为了进一步评估其无抗原疫苗和化学疗法组合的功效,研究小组分析了单独接受该组合或无抗原疫苗的AML小鼠的骨髓。他们发现单独的无抗原疫苗并不能有效地减少骨髓中AML细胞的数量或增加活性T细胞的数量,但是联合疗法实现了这两个目标。该组合还导致骨髓中调节性T细胞(Tregs)数量减少,从而抑制了免疫功能,被认为是骨髓中AML细胞可以逃避免疫检测的主要原因。 





